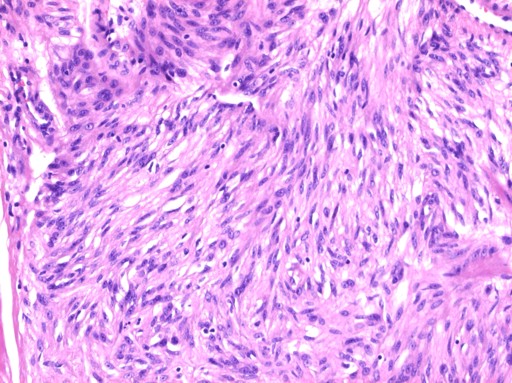

MULTIMEDIA ARTICLE - Clinical Imaging and Video
JOP. J Pancreas (Online) 2010 Jul 5; 11(4):396-400.
En Bloc Resection of the Pancreatic Head and Second Part of Duodenum for a Duodenal Gastrointestinal Stromal Tumor: A Multi-Media Report
Adam E Frampton1, Jan J Bong2, Charis Kyriakides1, Patrizia Cohen3, Long R Jiao1
1Hepato-Pancreato-Biliary Surgical Unit, Department of Surgery and Cancer, Imperial College, Hammersmith Hospital Campus. London, United Kingdom. 2Department of Surgery, National University of Malaysia. Bangi, Selangor, Malaysia. 3Department of Histopathology, Imperial College NHS Trust, Charing Cross Hospital. London, United Kingdom
Summary
Duodenal gastrointestinal stromal tumors are rare tumors. When these tumors arise from the second part of the duodenum they can easily be misdiagnosed as a pancreatic head cancer. A case of a 37-year-old female presenting with a one-year history of right upper quadrant pain is described here, who was subsequently found to have a mass in the head of the pancreas. Computed tomography scans showed a 2 cm hypervascular lesion lying between the head of pancreas and the second part of the duodenum, suggestive of a neuroendocrine tumor, and confirmed by endoscopic ultrasound scan. She underwent a pancreatic head resection with duodenal segmentectomy. Histopathological and immunohistochemical analysis revealed the tumor to be peri-ampullary duodenal gastrointestinal stromal tumor not invading the pancreas. Duodenal gastrointestinal stromal tumor can have a wide spectrum of clinical presentation. The accurate diagnosis of duodenal gastrointestinal stromal tumor is essential for determining the appropriate surgical intervention. In our case, a conservative surgical approach was utilised therefore avoiding a formal pancreaticoduodenectomy.
Introduction
Gastrointestinal stromal tumors (GISTs) are the commonest primary mesenchymal tumors arising in the gastrointestinal tract [1, 2, 3]. They are commonest in the stomach (60-70%), but also occur in the small intestine (20-30%), colorectum (less than 10%) and oesophagus (5%) [2, 4, 5]. Only 3-5% of GISTs occur in the duodenum [4, 5, 6] and this accounts for 10-33% of all malignant duodenal tumors [7]. Clinical presentation is dependent on the tumor size and degree of mucosal ulceration. Duodenal GISTs commonly present with GI bleeding (20-50%) and chronic anaemia, epigastric pain (50-70%), a palpable mass, and at a later stage, intestinal or biliary obstruction [4, 8, 9, 10, 11].
Most GISTs arise within the muscularis propria of the stomach or intestinal wall and usually grow expansively without being invasive. They follow three patterns of growth: endophytic (submucosal or intramural), "dumbbell" (intraluminal and extraluminal components), and exophytic or extraluminal (resulting in adjacent organ displacement) [5, 12, 13]. Lymphatic involvement is not common and these tumors rarely metastasise to the liver or peritoneum [1, 6, 8, 14]. Local resection is therefore a possibility, but a conservative surgical approach depends on accurate pre-operative diagnosis.
GISTs can be difficult to diagnose as their clinical manifestation is highly variable. As a result they have a wide spectrum of radiologic appearances [10]. We describe a rare case of a duodenal GIST mimicking pancreatic cancer, which was successfully treated by a duodenal-preserving resection of the head of pancreas. This case highlights the importance of accurate pre-operative diagnosis and differentiation of duodenal GISTs from other pancreatic tumors and reviews the surgical options.
Case History
A 37-year-old Caucasian female was referred with a one-year history of recurrent right upper quadrant pain associated with sweating and nausea. She also had symptoms of hot flushes and palpitations, but no diarrhoea or weight loss. There was no significant past medical history or family history. Physical examinations were unremarkable. Initial investigations revealed normal full blood counts, urea and electrolytes, liver function tests and coagulation screen. Her gut hormone profile was normal, as were chromogranin A and B levels. Abdominal ultrasonography showed sludge within the gallbladder as well as a lesion in the head of the pancreas. Abdominal computed tomography (CT) scans showed a 2 cm hypervascular lesion lying between the head of pancreas and the second part of the duodenum (Figure 1). Endoscopic ultrasound scan (EUS) revealed a 1.8x1.5 cm hypervascular lesion in the head of the pancreas. No endoscopic fine-needle aspiration (FNA) cytology was carried out as the lesion appeared very vascular and the risk of bleeding was not warranted given the plan for operative excision. No specific mucosal abnormalities were reported in the duodenum. A pre-operative diagnosis of either a neuroendocrine or a solid pseudopapillary tumor of the pancreas was made based on the imaging findings.

|
Figure 1. Abdominal computed tomography scan showing 2 cm hypervascular mass lying between the head of the pancreas and the second part of the duodenum easily mistaken for a neuroendocrine tumor or ductal adenocarcinoma. |
|
|
Following a roof top incision, a laparotomy was performed with an examination of the pancreas. This revealed a hard mass in the head of the pancreas and dissection in preparation for a pancreaticoduodenectomy was done. The first part of the duodenum was transected just distal to the pylorus and the pancreatic neck was transected at the level of portal vein. A limited "en bloc" resection of the second part of duodenum (D2) was performed with the head of the pancreas (Videoclip; Figures 2 and 3) to preserve the distal part of D1, a small part of the D1/D2 junction and the whole of D3 and D4. Reconstruction was carried out by first performing a pancreatico-gastrostomy and a Roux-en-Y loop anastomosis to the distal common bile duct. A duodeno-duodenal anastomosis was then performed with a tension-free anastomosis in two continuous layers. Operative time was 360 minutes with an estimated blood loss of 150 mL.

|
Figure 2. Intra-operative photo showing the excision of the second part of duodenum by LigaSureTM (Covidien, Boulder, CO, USA) device. The suction catheter is pointing at the transected neck of pancreas. |
|
|

|
Figure 3. Macroscopic view of the duodenal gastrointestinal stromal tumor protruding from the second part of duodenum and "pushing" onto the head of pancreas. |
|
|
|
Videoclip. Pancreatic head
resection with duodenal segmentectomy for a GIST in the second part of
duodenum. |
|
|
|
|
Her recovery was uneventful and she was discharged on the 15th day post-operatively.
Examination of the surgical specimen showed a well-circumscribed cystic mass in the duodenal wall just superior to the ampulla. Microscopic examination with H&E staining of the tumor showed spindle shaped and epithelioid cells with mild nuclear pleiomorphism (Figure 4). Immunohistochemistry revealed that the cells strongly expressed CD117 (Figure 5), with focal expression of CD34 and smooth muscle actin. Therefore, the final histology was consistent with the diagnosis of a duodenal GIST, abutting the pancreas without invasion. A complete excision (R0) was achieved. The small size of the tumor and low mitotic index (less than 1 per 50 high-power fields; HPF) indicates a low risk of recurrence.
|
Figure 4. H&E stain of the gastrointestinal stromal tumor demonstrated spindle cells with mitotic rate less than 1 per 50 high-power fields (magnification x100). |
|
|
|
|

|
Figure 5. Immunohistochemical analysis demonstrated the tumor cells are strongly positive for CD117 (c-kit) (brown). The tumor abuts the pancreatic head (light blue) without invasion (magnification x20). |
|
|
|
|
Discussion
Gastrointestinal stromal tumors are low-grade malignant mesenchymal tumors of the gastrointestinal tract and are believed to originate from the neoplastic transformation of the interstitial cells of Cajal (the gastrointestinal pacemaker cells) or their precursors [1, 3, 4], which are located between the longitudinal and circular layers of the muscularis propria [2]. These tumors commonly express the c-kit protein (CD117 positivity) and the myeloid stem cell antigen, CD34 [3].
The majority of duodenal GISTs are transmural or involve the external aspect of duodenum [11]. They most frequently arise from the second part of the duodenum where they push or infiltrate into the pancreas [11]. Miettinen et al. found that 11 (7%) of the 156 duodenal GISTs that they studied extended close to pancreas on microscopic examination, but were all limited by a "pushing border" [11].
An extensive search of the English literature found only two previous case reports [4, 5] and one case series [15] describing duodenal GISTs presenting as a pancreatic head cancers. The GISTs in the case reports were both also suspected to be neuroendocrine tumors and were treated by a pylorus-preserving pancreaticoduodenectomy and a segmental resection of the duodenum and duodenojejunostomy respectively. In the case series by Sandrasegaran et al., the pre-operative CT scans of 19 patients with a duodenal GIST were reviewed [15]. They found that 2 of the 19 scans were reported as possible pancreatic head cancers and both patients underwent a pancreaticoduodenectomy.
Duodenal GISTs can have an atypical presentation and we believe that the pre-operative diagnosis of these tumors is problematic and these difficulties are under-reported. The consequence is the over-treatment of these lesions with radical surgery. In our patient, the tumor had some radiological features of GIST such as hypervascularity and cystic areas, but had an atypical growth pattern (not obviously intraluminal or extraluminal) and was therefore difficult to distinguish from other tumors of the pancreatic head. GISTs form a gross mucosal ulceration in 50% of cases [10] and the intramural component can sometimes be seen as a submucosal bulge [4, 5, 11]; both of these features may aid diagnosis by endoscopy, but were not present in our patient. Endoscopic biopsy can also be misleading since GISTs can be covered by normal mucosa and sampling needs to be from deeper layers [16]. EUS can be useful in diagnosing submucosal tumors as it allows intramural scanning of all the layers of intestinal wall [16]. EUS-FNA cytology has a high sensitivity (78-100%) for GIST when compared to conventional endoscopic biopsy and when using immunohistochemical analysis [16, 17]. This preoperative information can significantly affect operative planning and direct the surgeon towards an early local resection rather than radical surgery. In retrospect, EUS-FNA may have helped in the pre-operative diagnosis of our patient, but would not have altered our surgical treatment.
Surgical treatment of GISTs involves complete removal of tumor with clear surgical margins and avoidance of tumor rupture [1]. Surgery for duodenal pathology is challenging because of its retroperitoneal position and shared blood supply with the pancreas [7]. The ideal surgical procedure for duodenal GIST depends on the size, anatomical location of the tumor (relationship to the ampulla) and possible adjacent organ involvement [8]. Surgery for duodenal GISTs tends to be a pancreaticoduodenectomy for larger tumors arising in close relation to the ampulla of Vater, and local resection or segmental duodenectomy for smaller lesions [2, 8]. It has been reported that 40% of duodenal GISTs are treated by pancreaticoduodenectomy [18]. It is acceptable to perform a local or segmental resection of the duodenum when technically feasible as GISTs rarely metastasise to regional lymph nodes [6]. Wide resection margins are not required to improve long term prognosis since GISTs exhibit little submucosal spread [8]. Improvements in the knowledge and techniques of pancreatic resection have meant that duodenal resection can now be performed safely with or without preservation of the pancreatic head [6, 7, 19]. For neoplasms that arise in the infra-ampullary portion of the duodenum, a conservative duodenectomy that preserves the pancreas and the papilla can provide adequate tumor clearance, while avoiding the additional risk associated with the biliary and pancreatic anastomoses [6, 7, 18]. For supra-ampullary and peri-ampullary tumors, pancreaticoduodenectomy is normally indicated, although in some selected cases, local resection of the papilla (ampullectomy) is possible [7, 20]. GISTs involving the anti-mesenteric aspect of the duodenum have been successfully treated by partial duodenectomy with Roux-en-Y duodenojejunostomy to cover the duodenal defect [1].
In our case, we performed a pancreatic head resection with segmental duodenectomy, due to the proximity of the tumor to the ampulla of Vater, using the Nakao/Fernandez-Cruz method [19]. This technique can be used as an alternative for resecting duodenal GISTs that would previously have been treated with a pancreaticoduodenectomy. It allows for maximum preservation of the pancreatic and duodenal functions without compromising oncological principles. We are not aware of another video presentation of this technique being available in the literature.
There have been some large case series reported more recently reiterating the continued dilemma over the surgical treatment of duodenal GISTs [21, 22]. The literature search that we performed revealed that these lesions can be easily mistaken for an adenocarcinoma and this subsequently leads to treatment with a pancreaticoduodenectomy rather than an organ-sparing procedure.
Received April 13th, 2010 - Accepted April 30th, 2010
Key words Duodenum; Gastrointestinal Stromal Tumors; Pancreaticoduodenectomy
Conflict of interest None
Acknowledgment This case report was shown as an oral/video presentation at the 9th World Congress of the International Hepato-Pancreato-Biliary Association on April 22nd, 2010 in Buenos Aires, Argentina
Correspondence
Long
R Jiao
Hepato-Pancreato-Biliary Surgical Unit
Department of Surgery and Cancer
Imperial College, Hammersmith Hospital Campus
Du Cane Road
London, W12 0HS
United Kingdom
Phone: +44-(0)208.383.3937
Fax: +44-(0)208.383.3179
E-mail: l.jiao@imperial.ac.uk
References
1. Goh BK, Chow PK, Ong HS, Wong WK. Gastrointestinal stromal tumor involving the second and third portion of the duodenum: Treatment by partial duodenectomy and roux-en-Y duodenojejunostomy. J Surg Oncol 2005; 91:273-5. [PMID 16121353]
2. Gervaz P, Huber O, Morel P. Surgical management of gastrointestinal stromal tumors. Br J Surg 2009; 96:567-78. [PMID 19434705]
3. Agaimy A, Wunsch PH. Gastrointestinal stromal tumors: A regular origin in the muscularis propria, but an extremely diverse gross presentation. A review of 200 cases to critically re-evaluate the concept of so-called extra-gastrointestinal stromal tumors. Langenbecks Arch Surg 2006; 391:322-9. [PMID 16402273]
4. Kwon SH, Cha HJ, Jung SW, Kim BC, Park JS, Jeong ID, et al. A gastrointestinal stromal tumor of the duodenum masquerading as a pancreatic head tumor. World J Gastroenterol 2007; 13:3396-9. [PMID 17659684]
5. Uchida H, Sasaki A, Iwaki K, Tominaga M, Yada K, Iwashita Y, et al. An extramural gastrointestinal stromal tumor of the duodenum mimicking a pancreatic head tumor. J Hepatobiliary Pancreat Surg 2005; 12:324-7. [PMID 16133702]
6. Sakamoto Y, Yamamoto J, Takahashi H, Kokudo N, Yamaguchi T, Muto T, Makuuchi M. Segmental resection of the third portion of the duodenum for a gastrointestinal stromal tumor: a case report. Jpn J Clin Oncol 2003; 33:364-6. [PMID 12949065]
7. Spalding DR, Isla AM, Thompson JN, Williamson RC. Pancreas-sparing distal duodenectomy for infrapapillary neoplasms. Ann R Coll Surg Engl 2007; 89:130-5. [PMID 17346405]
8. Goh BK, Chow PK, Kesavan S, Yap WM, Wong WK. Outcome after surgical treatment of suspected gastrointestinal stromal tumors involving the duodenum: Is limited resection appropriate? J Surg Oncol 2008; 97:388-91. [PMID 18163461]
9. De Marco G, Roviello F, Marrelli D, De Stefano A, Neri A, Rossi S, et al. A clinical case of duodenal gastrointestinal stromal tumor with a peculiarity in the surgical approach. Tumori 2005; 91:261-3. [PMID 16206652]
10. Levy AD, Remotti HE, Thompson WM, Sobin LH, Miettinen M. Gastrointestinal stromal tumors: radiologic features with pathologic correlation. Radiographics 2003; 23:283-304. [PMID 12640147]
11. Miettinen M, Kopczynski J, Makhlouf HR, Sarlomo-Rikala M, Gyorffy H, Burke A, et al. Gastrointestinal stromal tumors, intramural leiomyomas, and leiomyosarcomas in the duodenum: a clinicopathologic, immunohistochemical, and molecular genetic study of 167 cases. Am J Surg Pathol 2003; 27:625-41. [PMID 12717247]
12. Pidhorecky I, Cheney RT, Kraybill WG, Gibbs JF. Gastrointestinal stromal tumors: Current diagnosis, biologic behavior, and management. Ann Surg Oncol 2000; 7:705-12. [PMID 11034250]
13. Ashkzaran H, Coenegrachts K, Steyaert L, De Wilde V, Van den Berghe I, Verstraete K, Casselman JW. Duodenal stromal tumor detected by CT-enteroclysis. JBR-BTR 2006; 89:306-7. [PMID 17274585]
14. Dematteo RP, Ballman KV, Antonescu CR, Maki RG, Pisters PW, Demetri GD, et al. Adjuvant imatinib mesylate after resection of localised, primary gastrointestinal stromal tumor: A randomised, double-blind, placebo-controlled trial. Lancet 2009; 373:1097-104. [PMID 19303137]
15. Sandrasegaran K, Rajesh A, Rushing DA, Rydberg J, Akisik FM, Henley JD. Gastrointestinal stromal tumors: CT and MRI findings. Eur Radiol 2005; 15:1407-14. [PMID 15761716]
16. Akahoshi K, Sumida Y, Matsui N, Oya M, Akinaga R, Kubokawa M, et al. Preoperative diagnosis of gastrointestinal stromal tumor by endoscopic ultrasound-guided fine needle aspiration. World J Gastroenterol 2007; 13:2077-82. [PMID 17465451]
17. Sepe PS, Moparty B, Pitman MB, Saltzman JR, Brugge WR. EUS-guided FNA for the diagnosis of GI stromal cell tumors: sensitivity and cytologic yield. Gastrointest Endosc 2009; 70:254-61. [PMID 19482280]
18. Mennigen R, Wolters HH, Schulte B, Pelster FW. Segmental resection of the duodenum for gastrointestinal stromal tumor (GIST). World J Surg Oncol 2008; 6:105. [PMID 18826622]
19. Nakao A, Fernandez-Cruz L. Pancreatic head resection with segmental duodenectomy: safety and long-term results. Ann Surg 2007; 246:923-8. [PMID 18043093]
20. Cavallini M, Cecera A, Ciardi A, Caterino S, Ziparo V. Small periampullary duodenal gastrointestinal stromal tumor treated by local excision: Report of a case. Tumori 2005; 91:264-6. [PMID 16206653]
21. Chung JC, Chu CW, Cho GS, Shin EJ, Lim CW, Kim HC, Song OP. Management and outcome of gastrointestinal stromal tumors of the duodenum. J Gastrointest Surg 2010; 14:880-3. [PMID 20140534]
22. Tien YW, Lee CY, Huang CC, Hu RH, Lee PH. Surgery for gastrointestinal stromal tumors of the duodenum. Ann Surg Oncol 2010; 17:109-14. [PMID 19841981]
